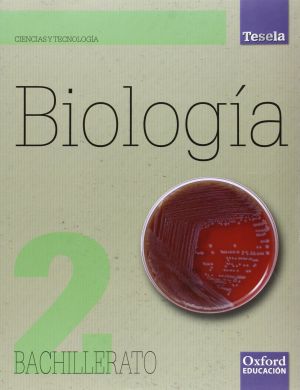

Resultados de búsqueda para: 'Quimica bachillerato 2 Santillana'
- Física 2º BachilleratoAñadir a la Lista de DeseosNo está disponible
-
-
-
-
- Biología 2º Bachillerato TeselaAñadir a la Lista de DeseosNo está disponible
-
- BIO (BIOLOGIA) 2º BACHILLERATOAñadir a la Lista de DeseosNo está disponible
- ANATOMÍA APLICADA 1º BachilleratoAñadir a la Lista de DeseosNo está disponible
-
-
- Historia de España 2º bachillerato 2023Añadir a la Lista de DeseosNo está disponible
Escribenos por WhatsApp